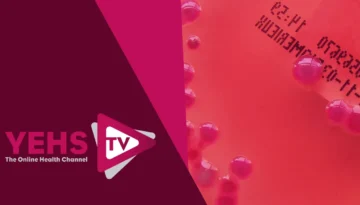
Superbugs

Sleeping Patterns: What is a Healthy Amount of Sleep?
Welcome to YEHS TV. Today we are joined by Dr Charlie Easmon, Medical Director at Your Excellent Health Service and we ask the question: Sleeping patterns – what is a healthy amount of sleep?

Welcome to YEHS TV. Today we are joined by Dr Charlie Easmon, Medical Director at Your Excellent Health Service and we ask the question: Sleeping patterns – what is a healthy amount of sleep?

Welcome to YEHS TV. Today we’re joined by Dr Charlie Easmon, Medical Director at Your Excellent Health Service and we discuss erectile dysfunction.

Welcome to YEHS TV. Today we’re joined by Dr Charlie Easmon, Medical Director at Your Excellent Health Service and we discuss hypertension and stroke.

Welcome to YEHS TV. Today we’re joined by Dr Charlie Easmon, Medical Director at Your Excellent Health Service and we discuss travel health.

Welcome to YEHS TV. Today we’re joined by Dr Charlie Easmon, Medical Director at Your Excellent Health Service and we look into mental health.
Welcome to YEHS TV. Today we’re joined by Dr Charlie Easmon, Medical Director at Your Excellent Health Service and we discuss superbugs.

Welcome to YEHS TV. Today we’re joined by Dr Charlie Easmon, Medical Director at Your Excellent Health Service and we discuss the National Health and IVF.

Welcome to YEHS TV. Today we’re joined by Dr Charlie Easmon, Medical Director at Your Excellent Health Service and we ask the question: Is eating bread bad for you? The truth behind gluten.

Welcome to YEHS TV. Today we’re joined by Dr Charlie Easmon, Medical Director at Your Excellent Health Service and we ask the question: Veganism – Can you be healthy without meat?

Welcome to YEHS TV. Today we’re joined by Dr Charlie Easmon, Medical Director at Your Excellent Health Service and we discuss depression, how to spot it in a friend and how to help.